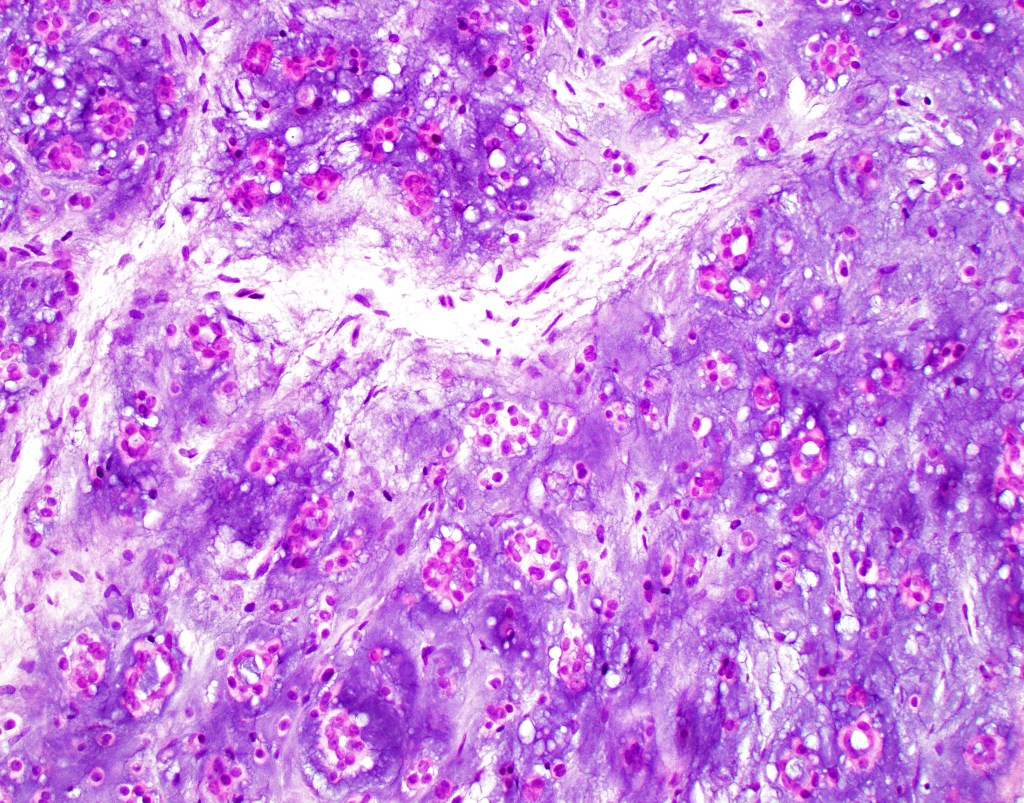
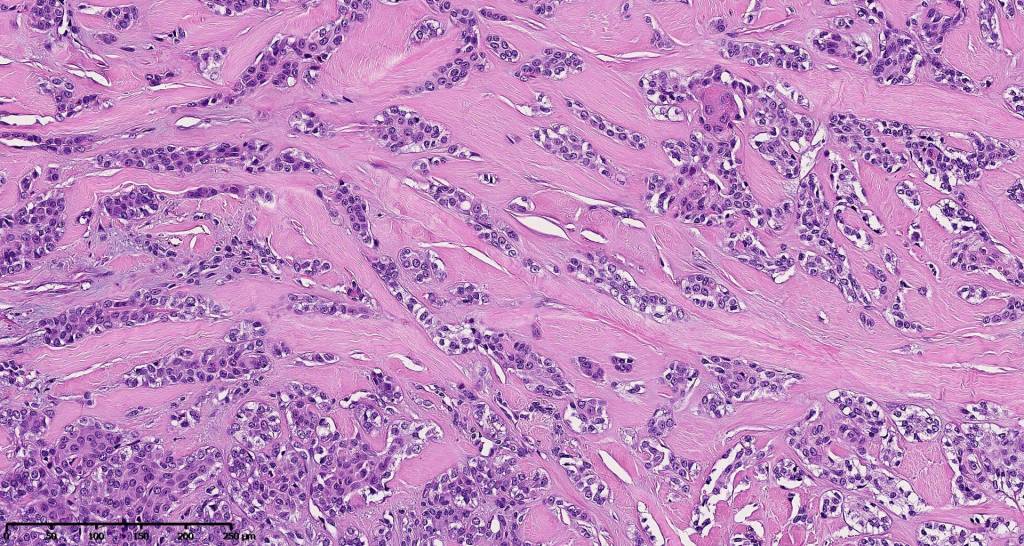
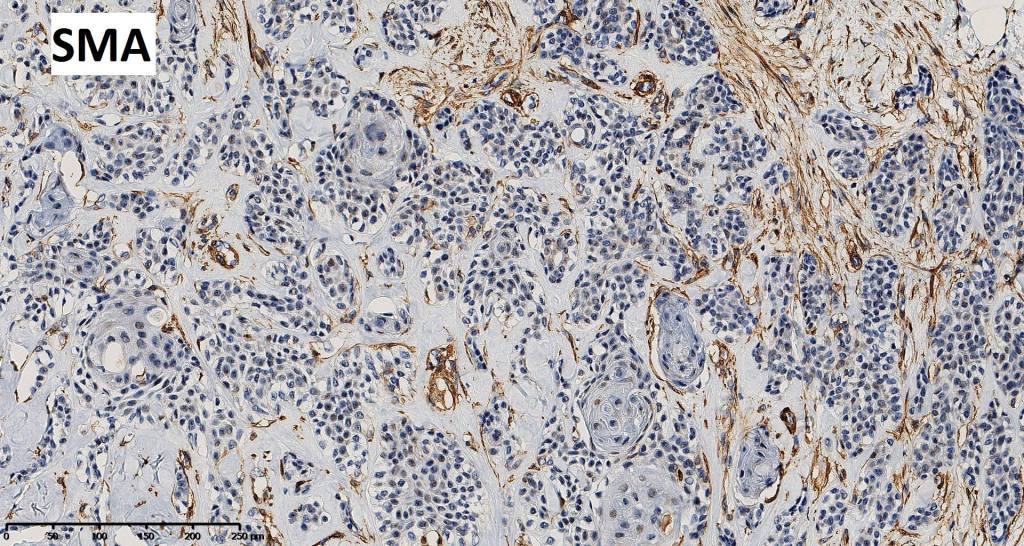
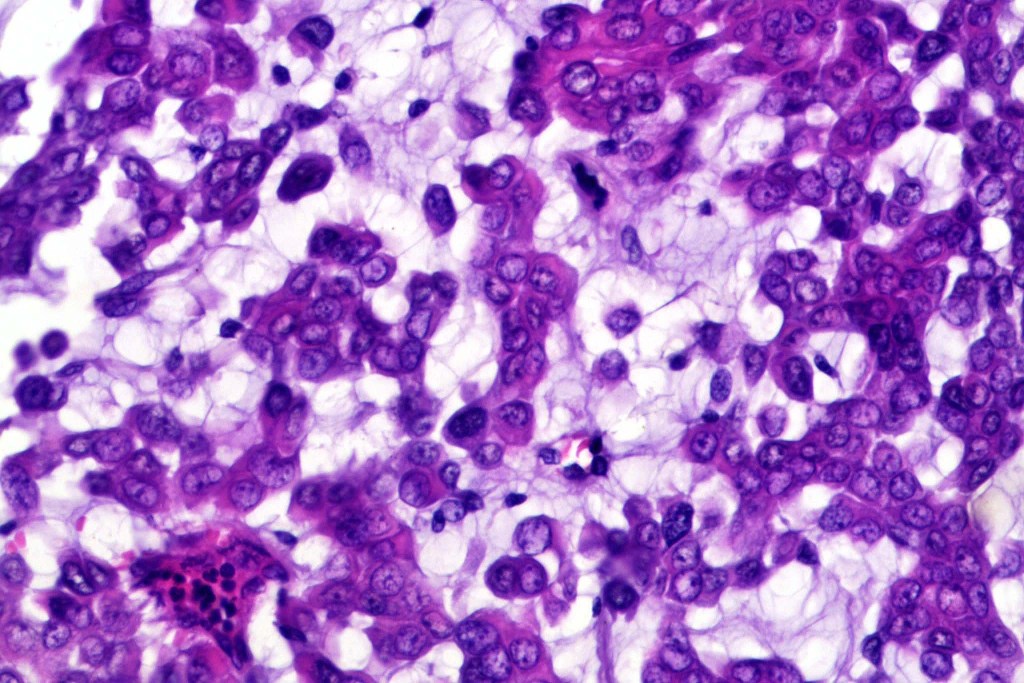
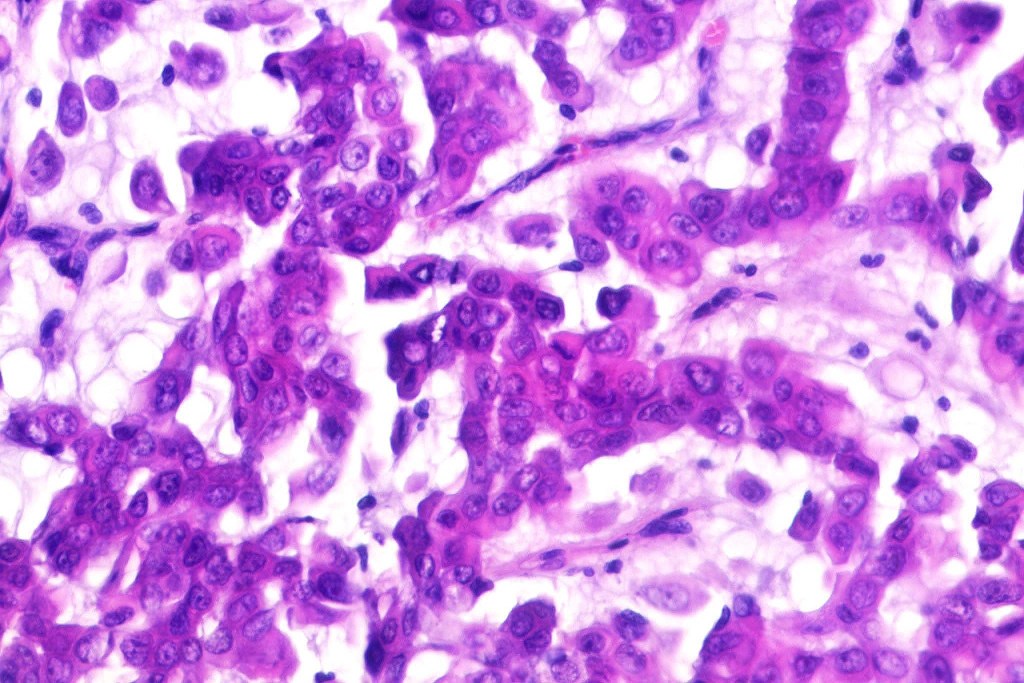
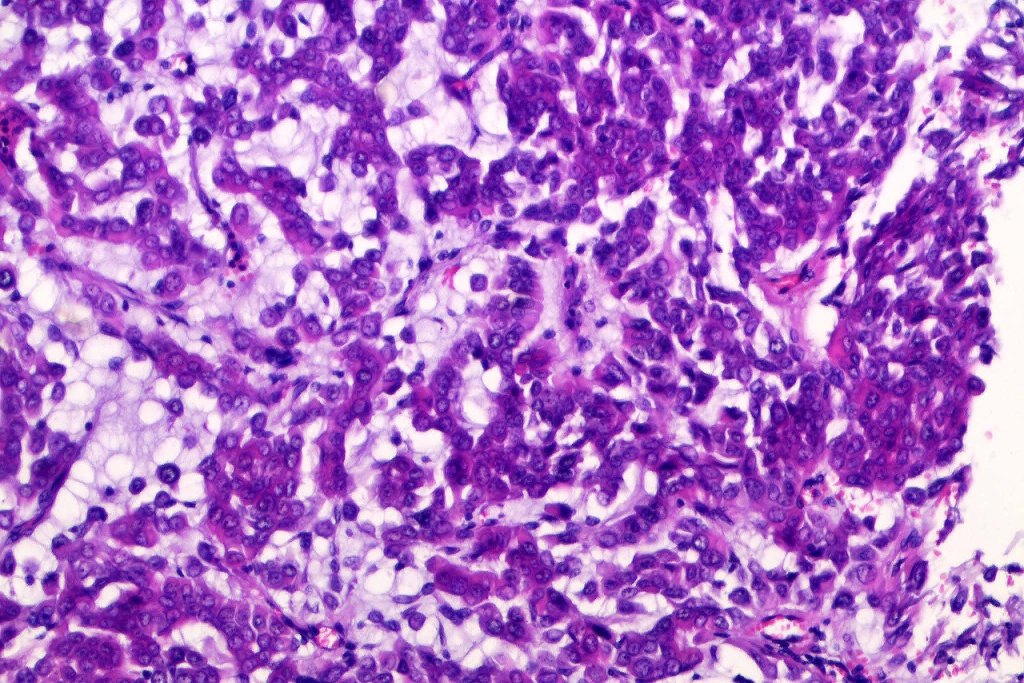
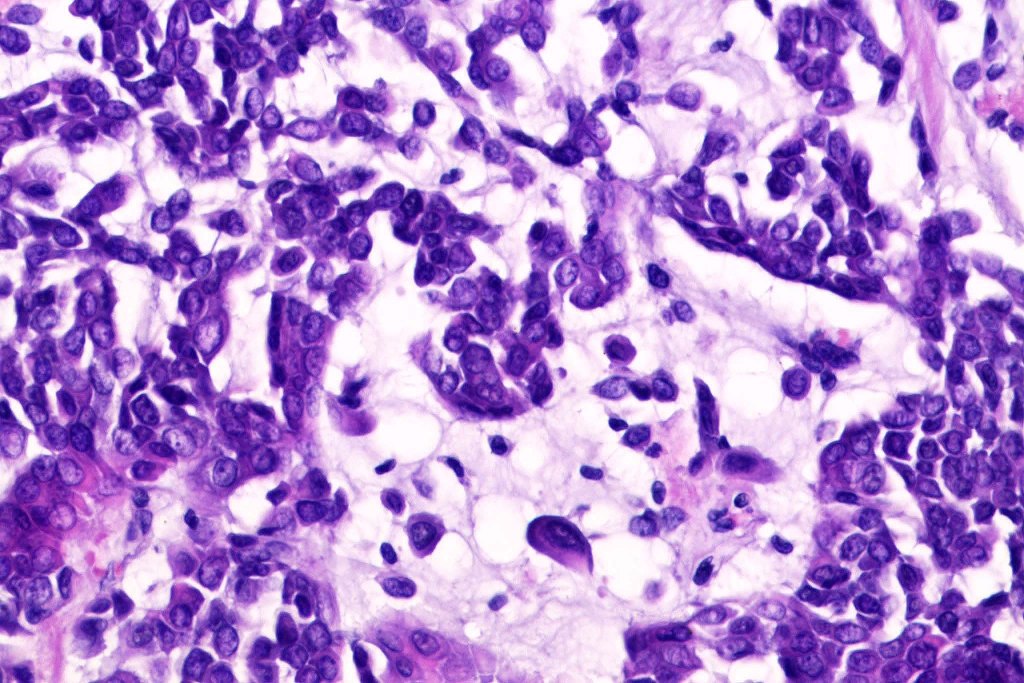

A relatively common benign sweat gland tumor characterised by an admixture of epithelial & mesenchymal elements. Typically thought of an apocrine gland tumor. Some authors recognise an eccrine variant. In my experience, such tumors are exceptionally rare. Many tumors show an admixture of both elements. Mixed tumor of the skin is mostly associated with rearrangment of PLAG1 gene with a much smaller group being associated with EWSR1.
Clinical features
•One of the more common sweat gland tumors
•M>F
•Middle aged
•Asymptomatic slowly growing, firm to hard dermal nodule,extension into subcutaneous fat sometimes present
•Head & neck++ with a predilection for nose, cheek, upper lip, scalp etc
•May also arise just about anywhere

Histological features
•Well circumscribed unencapsulated, nodular/multinodular silhouette composed of an admixture of epithelial & mesenchymal elements
•Often intensely basophilic due to mucinous deposits
•Mixed epithelial component including nests & cords of epithelium with abundant, eosinophilic cytoplasm & small vesicular nuclei
•Clear cell change
•Glandular differentiation sometimes showing apocrine differentiation
•Myoepithelial layer in glandular foci
•Mucinous metaplasia
•Ductal differentiation
•Cribriform/retiform appearance occasionally evident
•Mitoses very rare or absent
•No necrosis
•Plasmacytoid myoepithelial cells; clear cell change
•Follicular & sebaceous differentiation
•Exceptionally matricial change
•Keratocysts & squamous foci
•Stromal sclerosis & hyalinization
•Myxoid change
•Chondroid foci
•Fat (lipomatous mixed tumor)
•Calcification & osteoid
•So-called eccrine variant characterized by a pure population of small ducts compressed by dense collagen
•So-called atypical variant characterized by severe atypia of the myoepithelial component (multinucleate & bizarre forms); benign behavior
•Epithelial cells are EMA, CEA & GCDFP-15 +ve, myoepithelial cells are S100, SOX10, SMA & MSA +ve

Malignant mixed tumor
Clinical features
•Exceedingly rare
•De novo or arising within a pre-existent benign mixed tumor
•Distal extremities with a predilection for the foot
•F>M
•Elderly (18-89 years)
•Metastases 60% (lymph nodes, lung & bone), mortality 25%
Histological features
•Infiltrative growth pattern
•Nuclear pleomorphism, prominent nucleoli
•Marked mitotic activity
•Abnormal mitoses
•Lymphovascular invasion
•Carcinosarcoma
•IHC is similar the same as for the benign tumor

Leave a comment